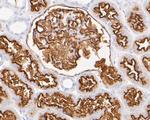
CD10 Antibody in Immunohistochemistry (Paraffin) (IHC (P))
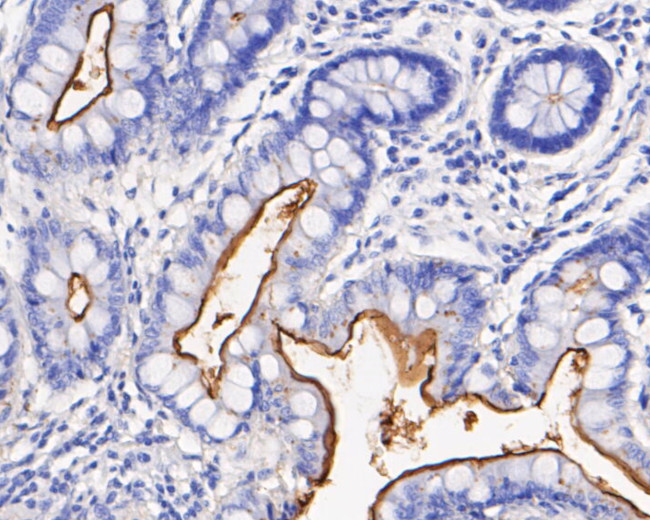
CD10 Antibody in Immunohistochemistry (Paraffin) (IHC (P))

Search
Huabio
CD10 Monoclonal Antibody (A1G4)
{{$productOrderCtrl.translations['antibody.pdp.commerceCard.promotion.promotions']}}
{{$productOrderCtrl.translations['antibody.pdp.commerceCard.promotion.viewpromo']}}
{{$productOrderCtrl.translations['antibody.pdp.commerceCard.promotion.promocode']}}: {{promo.promoCode}} {{promo.promoTitle}} {{promo.promoDescription}}. {{$productOrderCtrl.translations['antibody.pdp.commerceCard.promotion.learnmore']}}
图: 1 / 5
CD10 Antibody (EM1901-25) in IHC (P)

产品信息
EM1901-25
种属反应
宿主/亚型
分类
类型
克隆号
抗原
偶联物
形式
浓度
纯化类型
保存液
内含物
保存条件
运输条件
靶标信息
CD10, also known as the Common Acute Lymphocytic Leukemia Antigen (CALLA) and neutral endopeptidase (NEP), is a Zn2+-dependent metallo-peptidase with neutral metalloendopeptidase activity. It is a 100 kDa type II transmembrane glycoprotein encoded by a gene that exists in a single copy of greater than 45 kb. The 5' untranslated region of the CD10 gene is alternatively spliced, resulting in four separate mRNA transcripts, although the coding region remains unaffected by alternative splicing. CD10 is involved in the regulation of chemotactic and inflammatory processes involving neutrophils and plays a role in stromal cell-dependent B lymphopoiesis. It is expressed on immature B cells in adult bone marrow, mature B cells in germinal centers, and cells from patients with chronic myelocytic leukemia (CML). Additionally, CD10 is present on the cells of lymphoblastic, Burkitt's, and follicular germinal center lymphomas. Beyond the hematopoietic compartment, CD10 is highly expressed on the brush border of enterocytes and renal tubules and glomeruli, as well as on breast myoepithelial cells, bile canaliculi, and fibroblasts. CD10 cleaves peptides at the amino side of hydrophobic residues, inactivating several biologically active peptides, including endothelin, glucagon, gastrin, neurotensin, bradykinin, enkephalins, substance P, oxytocin, and others. Diseases associated with CD10 dysfunction include spinocerebellar ataxia 43 and Charcot-Marie Tooth Disease, highlighting its significance in both normal physiological processes and disease states.
仅用于科研。不用于诊断过程。未经明确授权不得转售。
篇参考文献 (0)
生物信息学
蛋白别名: Atriopeptidase; CALLA; CD10; Common acute lymphocytic leukemia antigen; Enkephalinase; membrane metallo-endopeptidase (neutral endopeptidase, enkephalinase, CALLA, CD10); membrane metallo-endopeptidase variant 1; membrane metallo-endopeptidase variant 2; NEP; Neprilysin; neprilysin-390; neprilysin-411; Neutral endopeptidase 24.11; SFE; Skin fibroblast elastase
基因别名: CALLA; CD10; CMT2T; EPN; MME; NEP; SFE
UniProt ID: (Human) P08473
Entrez Gene ID: (Human) 4311